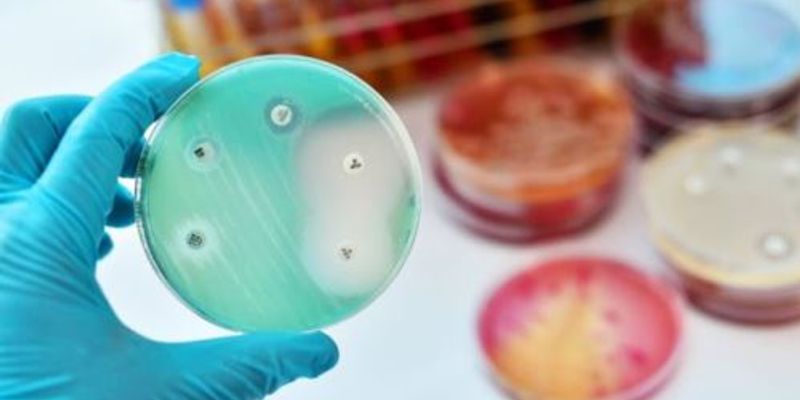

Antibiotic Resistance
Antibiotic Resistance: (AMR or AR) is the ability of a microbe to resist the effects of medication that once could successfully treat the microbe. The main term antibiotic resistance (AR or ABR) is a subset of AMR, as it applies only to bacteria becoming resistant to antibiotics.
What's Popular in Antibiotic Resistance
-
DEC 10, 2025MicrobiologyThere are many forms of Escherichia coli. Many are harmless members of the gut microbiome, but others can cause serious ...Written By: Carmen LeitchDEC 07, 2025MicrobiologyResearch has indicated that many common pollutants are harmful to the important microbes in the gastrointestinal tract.Written By: Carmen LeitchNOV 26, 2025MicrobiologyBacterial cells can easily swap bits of DNA, and many of those pieces of genetic material carry genes that confer resist ...Written By: Carmen LeitchOCT 16, 2025Clinical & Molecular DXIntroduction Antimicrobial resistance (AMR) in sexually transmitted infections (STIs) now poses a significant and escala ...JUN 15, 2025MicrobiologyA deadly bacterial pathogen that is often found in hospitals and frequently resistant to drugs, Pseudomonas aeruginosa, ...Written By: Carmen Leitch
DEC 10, 2025
Microbiology
There are many forms of Escherichia coli. Many are harmless members of the gut microbiome, but others can cause serious
...
Written By:
Carmen Leitch
DEC 07, 2025
Microbiology
Research has indicated that many common pollutants are harmful to the important microbes in the gastrointestinal tract.
Written By:
Carmen Leitch
NOV 26, 2025
Microbiology
Bacterial cells can easily swap bits of DNA, and many of those pieces of genetic material carry genes that confer resist
...
Written By:
Carmen Leitch
OCT 16, 2025
Clinical & Molecular DX
Introduction Antimicrobial resistance (AMR) in sexually transmitted infections (STIs) now poses a significant and escala
...
JUN 15, 2025
Microbiology
A deadly bacterial pathogen that is often found in hospitals and frequently resistant to drugs, Pseudomonas aeruginosa,
...
Written By:
Carmen Leitch
JUN 11, 2025
Microbiology
This new kind of drug pipeline was used to screen over one million interactions between small molecules and antibiotics,
...
Written By:
Carmen Leitch
MAY 23, 2025
Microbiology
For years, clinicians and scientists have known that many frontline antibiotics are becoming less reliable. Bacteria con
...
Written By:
Carmen Leitch
APR 28, 2025
Immunology
A study published in Frontiers explores the microbial diversity within hospital sink drains across multiple wards over a
...
Written By:
Greta Anne
APR 08, 2025
Microbiology
There are many different kinds of Escherichia coli bacteria. Some of them ..
Written By:
Carmen Leitch
-
Wastewater serves as a mirror of society, offering valuable insights into a wide range of parameters. Molecular biology leverages this potential by regular analysis of wastewater samples to...Speaker: Gabriela Eder, MSc
OCT 29, 2024 | 7:00 AM
Urinary tract infections (UTIs) are among the most prevalent infectious diseases, imposing a significant economic burden on healthcare systems. Traditional microbiological diagnostics for UT...
OCT 23, 2024 | 9:00 AM
The increasing emergence of carbapenem-resistant organisms (CRO), including Enterobacterales (CRE), Pseudomonas aeruginosa (CRPA) and Acinetobacter baumannii (CRAB), is a major public health...
Speaker:
Chunye Lu, PhD, MSc, PHM
, Vida Mofidi M.P.H., M(ASCP)CM
Sponsored By: Bruker Microbiology & Infection Diagnostics
OCT 12, 2023 | 6:00 AM
Acute coughing is one of the most common reasons for consulting in primary care thus driving considerable antibiotic use and health-care costs. Currently, identification of microbial etiolog...
Speaker:
Prof. Dr. Greet Ieven, PhD
, Israel Figueroa
, Jelena Feenstra, PhD
Sponsored By: Thermo Fisher Scientific
SEP 28, 2023 | 10:00 AM
Accurate diagnosis of H. pylori infection remains both crucial and challenging today. In line with current guidelines, confirming eradication after antibiotic treatment is essential. Diagnos...
Wastewater serves as a mirror of society, offering valuable insights into a wide range of parameters. Molecular biology leverages this potential by regular analysis of wastewater samples to...
Speaker:
Gabriela Eder, MSc
OCT 29, 2024 | 7:00 AM
Urinary tract infections (UTIs) are among the most prevalent infectious diseases, imposing a significant economic burden on healthcare systems. Traditional microbiological diagnostics for UT...
OCT 23, 2024 | 9:00 AM
The increasing emergence of carbapenem-resistant organisms (CRO), including Enterobacterales (CRE), Pseudomonas aeruginosa (CRPA) and Acinetobacter baumannii (CRAB), is a major public health...
Speaker:
Chunye Lu, PhD, MSc, PHM
, Vida Mofidi M.P.H., M(ASCP)CM
Sponsored By: Bruker Microbiology & Infection Diagnostics
OCT 12, 2023 | 6:00 AM
Acute coughing is one of the most common reasons for consulting in primary care thus driving considerable antibiotic use and health-care costs. Currently, identification of microbial etiolog...
Speaker:
Prof. Dr. Greet Ieven, PhD
, Israel Figueroa
, Jelena Feenstra, PhD
Sponsored By: Thermo Fisher Scientific
SEP 28, 2023 | 10:00 AM
Accurate diagnosis of H. pylori infection remains both crucial and challenging today. In line with current guidelines, confirming eradication after antibiotic treatment is essential. Diagnos...
Helicobacter pylori is the primary cause of 78% of gastric cancer cases, providing an opportunity to prevent cancer by controlling a single bacterial pathogen within the complex gastric micr...
AUG 08, 2023 | 8:00 AM
Antibiotic resistance is a global health threat and an emerging micropollutant of concern. Monitoring antibiotic resistance genes (ARGs) from environmental samples requires advanced molecula...
JUN 08, 2023 | 9:00 AM
In the emergency department, distinguishing between bacterial and viral infections can be challenging, leading to inappropriate use of antibiotics that may contribute to the development of b...
APR 11, 2023 | 11:00 AM
Date: April 11, 2023 Time: 11:00am (PDT), 2:00pm (EDT), 8:00pm (CEST) Antimicrobial resistant (AMR) infections are on the rise causing approximately 1.3M deaths each year due to patients suc...
-
SEP 08, 2021 | 6:00 AM PDTLuminex's xMAP® Technology enables the evaluation of up to 500 analytes simultaneously in a single well, known as multiplexing. xMAP Technology uses color-coded microspheres as the substrate...APR 07, 2021 | 6:30 AM PDTAccelerating Cell and Gene Therapy Treatments Since the first approved gene therapy trial in 1990, interest in cell and gene therapies has increased rapidly, changing the course of research...JUN 20, 2019 | 6:00 AM PDTOur 4th Annual Event in the Precision Medicine Virtual Event Series is now available On-Demand!...APR 25, 2019 | 6:00 AM PDTOur 1st Annual Event in the Infectious Disease Virtual Event Series 2019 is now available On-Demand!...
SEP 08, 2021
| 6:00 AM PDT
Luminex's xMAP® Technology enables the evaluation of up to 500 analytes simultaneously in a single well, known as multiplexing. xMAP Technology uses color-coded microspheres as the substrate...
APR 07, 2021
| 6:30 AM PDT
Accelerating Cell and Gene Therapy Treatments Since the first approved gene therapy trial in 1990, interest in cell and gene therapies has increased rapidly, changing the course of research...
JUN 20, 2019
| 6:00 AM PDT
Our 4th Annual Event in the Precision Medicine Virtual Event Series is now available On-Demand!...
APR 25, 2019
| 6:00 AM PDT
Our 1st Annual Event in the Infectious Disease Virtual Event Series 2019 is now available On-Demand!...
JAN 31, 2019
| 6:00 AM PST
Labroots is excited to present the 1st annual event in the BioProcessing Virtual Event Series....
SEP 12, 2018
| 6:00 AM PDT
Join Labroots in bringing the microbiology research community together at the 3rd Annual Event in the Microbiology and Immunology Virtual Event Series! During the free...
JUN 20, 2018
| 6:00 AM PDT
Our 3rd Annual Event in the Precision Medicine Virtual Event Series is now available On Demand!...
APR 11, 2018
| 6:00 AM PDT
Our 3rd Annual Event in the Molecular Diagnostics Virtual Event Series is now available On Demand!...